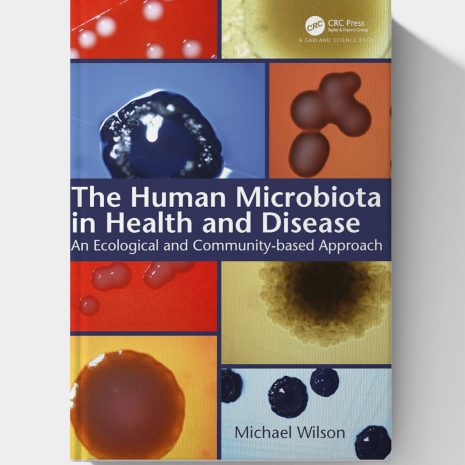

The Human Microbiota in Health and Disease: An Ecological and Community-based Approach (1st Edition)
By: Mike Wilson (Author)
PDF: 55.8MB
A human being consists of a mammalian component and a multiplicity of microbes, collectively referred to as the “microbiota” or “microbiome,” with which it has a symbiotic relationship. The microbiota is comprised of a variety of communities, the composition of each being dependent on the body site it inhabits. This community variation arises because the numerous locations on a human being provide very different environments, each of which favors the establishment of a distinct microbial community. Each community consists of bacteria, fungi, and viruses, with, in some cases, archaea and/or protozoa.
It is increasingly being recognized that the indigenous microbiota plays an important role in maintaining the health of its human host. However, changes in the overall composition of a microbial community at a body site, or an increase in the proportion of a particular species in that community, can result in disease or other adverse consequences for the host.
The Human Microbiota in Health and Disease: An Ecological and Community-Based Approach describes the nature of the various communities inhabiting humans and their important roles in human health and disease. It discusses techniques used to determine microbial community composition and features a chapter devoted to the many factors that underlie this mammalian–microbe symbiosis. Uniquely, the book adopts an ecological approach to examining the microbial community’s composition at a particular body site and why certain factors can shift a community from an eubiotic to a dysbiotic state.
The book is for undergraduates and postgraduates on courses with a module on the indigenous microbiota of humans. It will also be useful to scientists, clinicians, and others seeking information on the human microbiota and its role in health and disease.
PDF Preview

Reviews
There are no reviews yet.